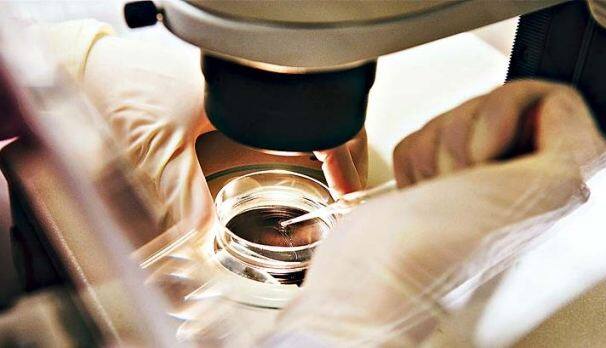
Preserving Fertility Can Be Expensive For Cancer Patients कैंसर पीड़ित लड़कों की प्रजनन क्षमता सुरक्षित रखने के लिए नई तकनीक

एक्सप्लोरर
कैंसर पीड़ित लड़कों की प्रजनन क्षमता सुरक्षित रखने के लिए नई तकनीक
वॉशिंगटन: वैज्ञानिकों ने ऐसा तरीका खोज निकाला है जिससे कैंसर का उपचार करवाने वाले युवकों की प्रजनन क्षमता जोखिम में नहीं पड़ेगी और उनके शुक्राणु स्टेम सेल संरक्षित किए जा सकेंगे. वयस्क पुरूष रेडिएशन या कीमोथरेपी का इलाज करवाने से पहले अपने शुक्राणु फ्रोजन करवा सकते हैं जिससे प्रजनन क्षमता सुरक्षित रह सकती है. लेकिन लड़के जो जवानी की दहलीज तक नहीं पहुंचे है और उनके शुक्राणु स्टेम सेल निकालकर ऐसी तकनीक के इंतजार में फ्रोजन कर लिए जाते हैं जिसकी मदद से शुक्राणुओं को संवर्धित करके उन्हें वापस वीर्यकोष में रख दिया जाए ताकि वयस्क होने पर शुक्राणुओं का उत्पादन हो सके. वॉशिंगटन स्टेट यूनिवर्सिटी में सहायक प्राध्यापक जोन ओटले और उनके सहयोगी ऐसी तकनीक विकसित करने में जुटे हैं. ओटले ने कहा, ‘‘मुझे लगता है कि यह मानक बन जाएगा जहां हर कोई अपनी कोशिकाओं को संवर्धित करवा सकेगा. कैंसर पर नियंत्रण के बाद जीवन की गुणवत्ता का बड़ा सवाल खड़ा हो जाता है जिसमें सामान्य प्रजनन शामिल है.’’ संवर्धन के दौरान नाइट्रोजन के इस्तेमाल से ऑक्सीजन को घटाकर देने पर वैज्ञानिकों ने पाया इससे ऐसे स्टेम सेलों का प्रतिशत कहीं ज्यादा बढ़ जाता है जिन्हें वीर्यकोष में डालने पर वे सामान्य शुक्राणु बनाने में सक्षम होते हैं.
Check out below Health Tools-
Calculate Your Body Mass Index ( BMI )
और पढ़ें
Source: IOCL
























